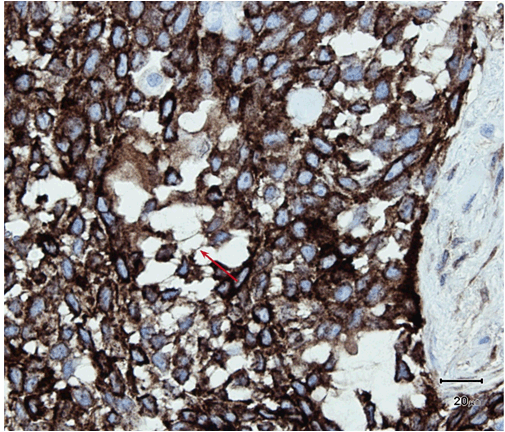

| Table of Contents |  |
|
Case Report
| ||||||
| Aggressive extraocular sebaceous carcinoma metastasizing to multiple visceral sites | ||||||
| Benjamin Presman1, Ilaria Tocco-Tussardi2, Lars Jørgensen3, Lene Birk-Sørensen1 | ||||||
|
1MD, Department of Plastic Surgery, Aalborg University Hospital, Aalborg, Denmark.
2MD, Department of Plastic Surgery, Uppsala University Hospital, Uppsala, Sweden. 3MD, Institute of Pathology, Vendyssel Hospital, Vendyssel, Denmark. | ||||||
| ||||||
|
[HTML Abstract]
[PDF Full Text]
[Print This Article]
[Similar article in Pumed] [Similar article in Google Scholar] |
| How to cite this article: |
| Presman B, Tocco-Tussardi I, Jørgensen L, Birk-Sørensen L. Aggressive extraocular sebaceous carcinoma metastasizing to multiple visceral sites. J Case Rep Images Oncology 2015;1:23–27. |
|
Abstract
|
|
Introduction:
Extraocular sebaceous carcinoma (SC) is a rare neoplasm with only 130 previous reported cases. Traditionally, extraocular sebaceous carcinoma is considered less aggressive in comparison to the ocular type. However, recent studies show that extraocular SC may lead to widespread disseminated metastatic disease in 21% of cases.
Case Report: We report a case of a previously healthy man who developed extraocular sebaceous carcinoma on his lower back. A month later, the patient presented with hemoptysis, hip-, and abdominal pain. Magnetic resonance imaging confirmed the presence of lung, liver and bone metastases. The patient was initially misdiagnosed with squamous cell carcinoma, but immunohistochemistry concluded the correct diagnosis to be extraocular sebaceous carcinoma. The patient died shortly after diagnosis. Conclusion: Our case supports the recent shift in paradigm of extraocular SC's ability to metastasize. Also, we review the current reported cases and show a 60% occurrence of lymph node involvement in the cases of metastasizing extraocular SC. These previous cases and the present case report confirm the need to consider either sentinel node biopsy or lymphadenectomy in the primary management of these patients. | |
|
Keywords:
Extraocular, Metastasis, Sebaceous carcinoma, Squamous cell carcinoma
| |
|
Introduction
| ||||||
|
Sebaceous carcinoma (SC) is a rare neoplasm that is classified in two main variants on the basis of its location, ocular or extraocular. The extraocular type is by far the least common, accounting for 25% with approximately 130 previous reported cases [1]. Around 70% of these occur in the head and neck region with the parotid gland being the most common location [2]. Traditionally, extraocular SC has been considered less aggressive in comparison to ocular SC. However, recent studies show that extraocular SC may lead to widespread disseminated metastatic disease in 21% of cases, which makes diagnosis and treatment vital [3]. The cause of most extraocular SC is unknown. There is an association Muir-Torre syndrome (MTS) [4]. MTS is an autosomal dominant disorder defined by the combination of a sebaceous gland tumour and at least one visceral carcinoma, most frequently a gastrointestinal cancer. The spectrum of cancers and the germline mutation-characteristics of MTS have suggested that it represents a phenotypic variant of hereditary nonpolyposis colorectal cancer (HNPCC)/Lynch syndrome [4]. We report a case of a 61-year-old male with extraocular SC who developed disseminated metastatic disease shortly after a biopsy of the primary neoplasm. Also, we review the reported cases of disseminated metastatic disease on the basis extraocular SC. | ||||||
|
Case Report
| ||||||
|
A 61-year-old male was presented to his dermatologist with a solitary nodular dermal lesion on his lower back (1.5x2 cm). He was otherwise well and was taking no medication. A biopsy demonstrated squamous cell carcinoma (SCC), and the patient was referred to our service for complete local excision. On follow-up, a month later, the patient presented with hemoptysis, hip-, and abdominal pain. Magnetic resonance imaging (MRI) scan confirmed the presence of lung, liver, and bone multiple metastases. As planned, a complete local excision with a 7.5 mm margin was performed. Histology confirmed the diagnosis of SCC. Furthermore, the patient had developed another solitary dermal lesion localized to the chin. This lesion was not present only a month prior during the visit to the dermatologist. A biopsy from this lesion also demonstrated SCC. The specimens from the back and chin were later studied with immunohistochemistry. The morphology suggested SC, with the tumor showing a solid arrangement of cells with nuclear pleomorphism, atypical mitosis, basophilic and vacuolated cytoplasm (Figure 1) and (Figure 2). In addition, immunohistochemistry showed tumor positive for epithelial marker Ber-EP4, pancytokeratin (Kl1) and epithelial membrane antigen (EMA) (Figure 3). Reactivity for p53 and proliferating cell nuclear antigen (Ki67) was high, showing 80–90% hot spots labeling of the tumor cells (Figure 4) and (Figure 5). Immunoreactivity levels of cancer protein p53 and Ki67 above 10 and 25% indicated a poor prognosis (Figure 6). It was then concluded that the correct diagnosis of both tumors was in fact SC and not SCC. The condition of the patient deteriorated drastically during the next days. He was admitted to an oncology department for further examination and there received palliative radiotherapy. Three weeks later he was discharged to a hospice where he soon died. | ||||||
| ||||||
| ||||||
| ||||||
| ||||||
| ||||||
|
Discussion
| ||||||
|
This case report shows a previously healthy man who developed SC and died within three months. He had no family history of hereditary cancer or sebaceous tumor and an examination of the specimens from the back and chin excluded mismatch repair deficiency as the cause of the cancer. MTS is therefore unlikely. The patient was initially misdiagnosed with SCC. The diagnosis of SC is extremely difficult due to the lack of clinical and histopathological pathognomonics. Incorrect initial histopathological diagnosis has been reported in 40–75% of cases, and the skin lesions are most often misdiagnosed as SCC [2]. It is, therefore, likely that the true number of incidences is underreported. It is generally been accepted that the extraocular type metastasize infrequently and behave less aggressively. However, including the present case, we have found 26 cases of metastasizing extraocular SC reported in literature, ten of which died as a result of visceral metastasis (Table 1). This challenges the previous perspective. Our case did not undergo autopsy, which is a bias to a definite conclusion, but MRI scan showed multiple sites of suspected metastasis after presentation of the extraocular dermal lesion on the back. The final diagnosis of aggressive and disseminated SC is supported by the fact that the patient developed a second extraocular SC within only one month. Further, being an extremely rare malignancy there are no existing guidelines for the management of advanced SC. At this time, the standard method of care for extraocular SC includes surgical resection with wide healthy margins. However, misleading histopathological conclusions of "clear margins" have been reported in 25% of cases thus increasing the risk for under-treatment [2]. Previous literature shows that lymph node involvement is seen in approximately 15–21% of all cases of SC. Table 1 gives 60% occurrence of lymph node involvement in the cases of metastasizing extraocular SC. These cases confirm the need to consider either sentinel node biopsy (SNB) or lymphadenectomy (LA) in the primary management. As a possible consequence of missing guidelines and because of extensive dissemination our patient received neither LA nor SNB. Postsurgical radiotherapy as adjuvant treatment has shown good results to improve local control and cosmetic results in ocular SC [5]. Our patient did not receive local postsurgical radiotherapy, but palliative radiotherapy with only little beneficial effect. Chemotherapy as adjuvant treatment has been reported to show good results in the treatment of aggressive extraocular SC [6], but controlled treatment data are lacking in this rare malignancy. | ||||||
| ||||||
|
| ||||||
|
Conclusion
| ||||||
|
In summary, extraocular sebaceous carcinoma (SC) is a rare and aggressive malignancy. Our case supports the recent shift in paradigm of extraocular SC's ability to metastasize. There remains a challenge of quick and correct diagnosis. When found it should raise suspicion for Muir-Torre syndrome (MTS) and alert to search for occult internal malignancy. Given the frequency of lymph node metastasis, we encourage the use of sentinel node biopsy (SNB) or lymphadenectomy (LA) in the primary management. | ||||||
|
References
| ||||||
| ||||||
|
[HTML Abstract]
[PDF Full Text]
|
|
Author Contributions
Benjamin Presman – Substantial contributions to conception and design, Acquisition of data, Analysis and interpretation of data, Drafting the article, Revising it critically for important intellectual content, Final approval of the version to be published Ilaria Tocco-Tussardi – Analysis and interpretation of data, Revising it critically for important intellectual content, Final approval of the version to be published Lars Jørgensen – Analysis and interpretation of data, Revising it critically for important intellectual content, Final approval of the version to be published Lene Birk-Sørensen – Analysis and interpretation of data, Revising it critically for important intellectual content, Final approval of the version to be published |
|
Guarantor of submission
The corresponding author is the guarantor of submission. |
|
Source of support
None |
|
Conflict of interest
Authors declare no conflict of interest. |
|
Copyright
© 2015 Benjamin Presman et al. This article is distributed under the terms of Creative Commons Attribution License which permits unrestricted use, distribution and reproduction in any medium provided the original author(s) and original publisher are properly credited. Please see the copyright policy on the journal website for more information. |
|
|